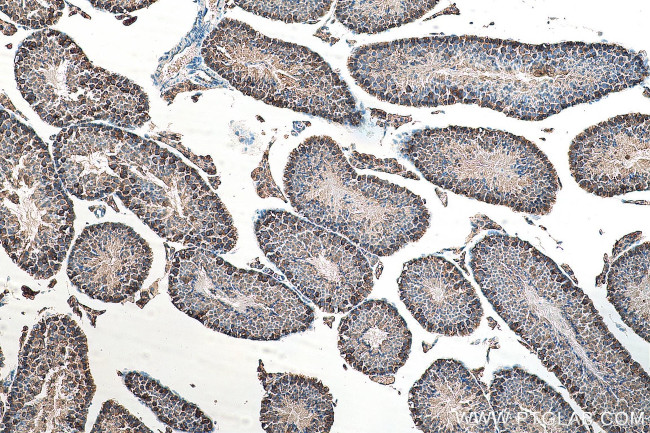
ATP6V1E1 Antibody in Immunohistochemistry (Paraffin) (IHC (P))
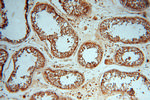
ATP6V1E1 Antibody in Immunohistochemistry (Paraffin) (IHC (P))

Search
Proteintech
ATP6V1E1 Polyclonal Antibody
{{$productOrderCtrl.translations['antibody.pdp.commerceCard.promotion.promotions']}}
{{$productOrderCtrl.translations['antibody.pdp.commerceCard.promotion.viewpromo']}}
{{$productOrderCtrl.translations['antibody.pdp.commerceCard.promotion.promocode']}}: {{promo.promoCode}} {{promo.promoTitle}} {{promo.promoDescription}}. {{$productOrderCtrl.translations['antibody.pdp.commerceCard.promotion.learnmore']}}
产品信息
15280-1-AP
种属反应
已发表种属
宿主/亚型
分类
类型
抗原
偶联物
形式
浓度
规格
纯化类型
保存液
内含物
保存条件
运输条件
产品详细信息
Immunogen sequence: MALSDADVQ KQIKHMMAFI EQEANEKAEE IDAKAEEEFN IEKGRLVQTQ RLKIMEYYEK KEKQIEQQKK IQMSNLMNQA RLKVLRARDD LITDLLNEAK QRLSKVVKDT TRYQVLLDGL VLQGLYQLLE PRMIVRCRKQ DFPLVKAAVQ KAIPMYKIAT KNDVDVQIDQ ESYLPEDIAG GVEIYNGDRK IKVSNTLESR LDLIAQQMMP EVRGALFGAN ANRKFLD (1-226 aa encoded by BC004443)
靶标信息
Subunit of the peripheral V1 complex of vacuolar ATPase essential for assembly or catalytic function. V-ATPase is responsible for acidifying a variety of intracellular compartments in eukaryotic cells.
仅用于科研。不用于诊断过程。未经明确授权不得转售。
生物信息学
蛋白别名: ATP6E; ATPase, H+ transporting lysosomal (vacuolar proton pump), 32 kDa; ATPase, H+ transporting, lysosomal 31kDa, V1 subunit E; ATPase, H+ transporting, lysosomal 31kDa, V1 subunit E1; ATPase, H+ transporting, V1 subunit E; H(+)-ATPase E-like protein; H(+)-transporting two-sector ATPase, 31kDa subunit; H+ ATPase subunit E; H+-transporting ATP synthase chain E, vacuolar; lysosomal 31kDa; p31; unnamed protein product; V-ATPase 31 kDa subunit; V-ATPase subunit E; V-ATPase subunit E 1; V-ATPase, subunit E; V-type proton ATPase subunit E 1; vacuolar H(+)-ATPase, E subunit; vacuolar H+ ATPase E1; Vacuolar proton pump subunit E 1; VATPase, H+ transporting, lysosomal V1 subunit E1
基因别名: 2410029D23Rik; ARCL2C; ATP6E; ATP6E2; ATP6V1E; ATP6V1E1; D6Ertd385e; E2; P31; Vma4
UniProt ID: (Human) P36543, (Mouse) P50518, (Rat) Q6PCU2
Entrez Gene ID: (Human) 529, (Mouse) 11973, (Rat) 297566